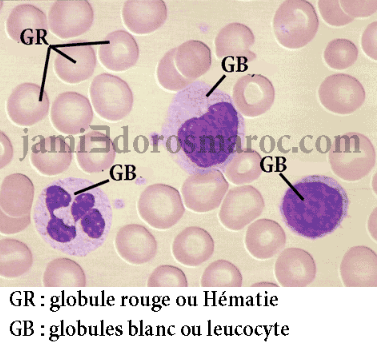

Explication : le sang et la circulation sanguine 3ac + pdf
le sang et la circulation sanguine chez l’homme 3ac
Le sang
Le sang est un liquide vital qui transporte les gaz respiratoires, les nutriments et les déchets dans tout le corps humain.
Les constituants du sang

Le sang est un liquide biologique composé :
- de 55 % de plasma,
- de 45 % de globules rouges,
- et de moins de 1 % de globules blancs et de plaquettes sanguines.
Le plasma

Le plasma est un liquide transparent et jaunâtre.
Il contient trois types de cellules : les globules rouges, les globules blancs et les plaquettes sanguines.
Le plasma contient une protéine appelée fibrinogène, qui peut se transformer en fibrine.
La fibrine forme des fils solides qui emprisonnent les cellules sanguines et permettent la coagulation du sang en cas de blessure.
Les plaquettes sanguines
Les plaquettes sont de petites particules sans noyau.
Elles jouent un rôle essentiel dans la coagulation du sang et permettent d’arrêter une hémorragie (saignement).
Les globules blancs
Les globules blancs (ou leucocytes) sont des cellules avec un noyau.
Ils assurent la défense de l’organisme contre les micro-organismes responsables d’infections.
Les globules rouges
Les globules rouges (ou hématies) sont des cellules sans noyau.
Elles sont essentielles pour transporter les gaz respiratoires :
- le dioxygène (O₂) des poumons vers les organes,
- et le dioxyde de carbone (CO₂) des organes vers les poumons.
Elles contiennent une protéine rouge appelée hémoglobine, qui donne la couleur au sang.
L’appareil circulatoire

L’appareil circulatoire est formé du cœur et des vaisseaux sanguins :
- les artères,
- les veines,
- et les capillaires sanguins.
Le sang circule ainsi :
Les artères transportent le sang du cœur vers les organes, où il passe dans les capillaires. Puis, le sang retourne au cœur par les veines.
Rôle du sang dans le transport
Le sang transporte :
- les gaz respiratoires entre les poumons et les organes,
- les nutriments absorbés dans l’intestin grêle jusqu’aux cellules.
Les échanges gazeux au niveau cellulaire

Chaque globule rouge contient de l’hémoglobine, riche en fer.
Cette protéine transporte :
- le dioxygène (O₂) des poumons vers les organes,
- et le dioxyde de carbone (CO₂) des organes vers les poumons.
Une petite partie du dioxygène est dissoute dans le plasma, mais la plus grande partie est transportée dans les globules rouges.
Une grande partie du dioxyde de carbone est dissoute dans le plasma, et une autre partie est transportée dans les globules rouges.
Le rôle de l’hémoglobine
L’hémoglobine se combine avec le dioxygène pour former l’oxyhémoglobine (HbO₂), de couleur rouge vif :
Hb + O₂ ⇄ HbO₂
Aux poumons, elle capte l’oxygène ; dans les organes, elle le libère.
L’hémoglobine transporte environ 98 % du dioxygène, le reste étant dissous dans le plasma.
Le dioxyde de carbone libéré par les cellules se fixe aussi sur l’hémoglobine pour former la carbaminohémoglobine (HbCO₂) :
Hb + CO₂ ⇄ HbCO₂
L’hémoglobine transporte 20 à 30 % du CO₂, tandis que 60 à 70 % circulent sous forme de composés dissous dans le plasma, et 7 à 10 % sont directement dissous dans le plasma.
Le transport des nutriments

Toutes les cellules baignent dans un liquide appelé lymphe interstitielle.
Ce liquide, semblable au plasma, permet les échanges de nutriments, de gaz et de déchets entre le sang et les cellules.
Il joue donc un rôle d’intermédiaire entre les deux.
Origine et formation de la lymphe
La lymphe interstitielle provient de la filtration du plasma à travers les parois des capillaires sanguins, sous l’effet de la pression du sang.
Elle remplit les espaces entre les cellules et leur apporte les éléments nutritifs tout en éliminant les déchets.
Une partie de cette lymphe passe ensuite dans des vaisseaux lymphatiques, formant la lymphe vasculaire.